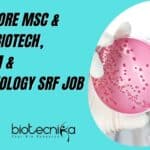
VIT Vellore SRF 2022

Home Search
biology - search results
If you're not happy with the results, please do another search
Telscie Genetics Biochem & Microbiology Project Fellow Recruitment
Telscie Genetics Biochem & Microbiology Project Fellow Recruitment
Telscie Genetics Pvt Ltd is a startup Biotech R&D Company making an entry into the field of...
ICGEB Biotech, Microbiology, Systems Biology JRF Job, Applications Invited
ICGEB JRF 2022 Job Opening For Biotech, Microbiology, Systems Biology
ICGEB JRF 2022 Job Opening For Biotech, Microbiology, Systems Biology. MSc biotechnology/ biochemical engineering/microbiology/systems biology...
10+ ICAR-NIVEDI Job Openings For Bioinformatics, Biotech, Biochem, Microbiology
ICAR-NIVEDI Jobs 2022 For Biotech, Biochem, Microbiology & Bioinformatics
ICAR-NIVEDI Jobs 2022 For Biotech, Biochem, Microbiology & Bioinformatics. More than 10 vacancies are available in...
IISc MSc NON-NET Biology Project Associate Recruitment, Apply Online
IISc MSc Biology Project Associate Recruitment For NON-NET Candidates, Apply Online
IISc MSc Biology Project Associate Recruitment For NON-NET Candidates, Apply Online. MSc biology jobs....
NIPGR PhD Plant Molecular Biology, Life Sciences, Biotech Research Job
NIPGR PhD Vacancy 2022 For Biotech, Life Sciences, Plant Mol Bio
NIPGR PhD Vacancy 2022 For Biotech, Life Sciences, Plant Mol Bio. PhD Biotechnology/ Life...
Danaher Biotech, Biochem, Microbiology Scientist Job Opening, Apply Online
Danaher Biotech, Biochem, Microbiology Scientist Job Opening, Apply Online
Danaher Biotech, Biochem, Microbiology Scientist Job Opening, Apply Online. Danaher Life Sciences companies jobs. Bengaluru scientist...
NIANP Research Fellow Job For Bioinformatics, Biotech, Microbiology & Mol Bio
NIANP Research Fellow Job For Biotech, Biochem, Microbiology & Mol Bio
NIANP Research Fellow Job For Biotech, Biochem, Microbiology & Mol Bio. Bengaluru jobs. NIANP...
NDDB Trainee Biotech, Botany, Zoology & Microbiology Job – Freshers Can Apply
NDDB Trainee Biotech, Botany, Zoology & Microbiology Job - Freshers Can Apply
NDDB Trainee Biotech, Botany, Zoology & Microbiology Job - Freshers Can Apply. Trainee...
NISER MSc & PhD Biology Project Associate Recruitment, Applications Invited
NISER Biology Project Associate - MSc & PhD Candidates
NISER Biology Project Associate - MSc & PhD Candidates. National Institute of Science Education and Research...
ICMR-NIN Biochem & Microbiology Young Professional Job Opening
ICMR-NIN Biochem & Microbiology Young Professional Job Opening
ICMR-NIN Biochem & Microbiology Young Professional Job Opening. MSc Biochemistry and Microbiology Project Young Professional position. Interested...
Cipla BSc Job Opening For Microbiology Candidates, Apply Online
Cipla BSc Job Opening For Microbiology Candidates, Apply Online
Cipla BSc Job Opening For Microbiology Candidates, Apply Online. BSc Microbiology Jobs. Interested and eligible applicants...
NIMHANS Microbiology & Virology Research Fellow Recruitment
NIMHANS Virology Job 2022 - SRF Vacancy Available
NIMHANS Virology Job 2022 - SRF Vacancy Available. MSc Virology/ Microbiology/ Medical Microbiology vacancy. MSc job at...
VIT Vellore MSc & MTech Biotech, Biochem & Microbiology SRF Job
VIT Vellore SRF 2022 Opening For MSc & MTech Candidates
VIT Vellore SRF 2022 Opening For MSc & MTech Candidates. MSc Biochemistry, Microbiology, Biotechnology SRF...
CSIR-National Institute of Oceanography MSc, MTech Biotech, Microbiology Multiple Research Jobs
CSIR-NIO Research Jobs For MSc, MTech Biotech, Microbiology
CSIR-NIO Research Jobs For MSc, MTech Biotech, Microbiology. CSIR-National Institute of Oceanography MTech Biotechnology Jobs. MSc Biotechnology...
Unilever R&D Associate Human Biology Job For MSc & BTech Biotech, Biochem, Life Sciences
Unilever R&D Associate Human Biology Job For MSc & BTech Biotech, Biochem, Life Sciences
Unilever R&D Associate Human Biology Job For MSc & BTech Biotech,...